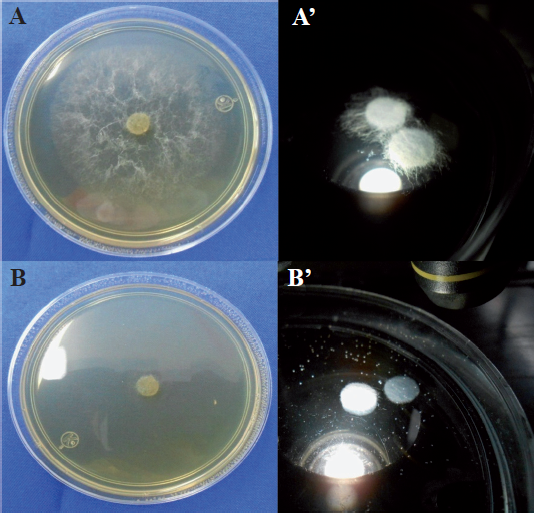

Resumen: Los fosfitos son compuestos derivados del ácido fosforoso empleados como alternativa para el control de organismos fitoparásitos y su eficacia se ha probado contra protozoarios, oomycetes, hongos, bacterias y nematodos; sin embargo, en comparación con los fungicidas convencionales sintetizados, generalmente son menos eficaces para disminuir el daño por fitopatógenos. El ion fosfito es fácilmente transportado en las plantas vía xilema y floema, por lo que se ha utilizado en aplicación foliar, baño a la raíz y cuello de la planta, inyección al tronco, a través de riego por goteo mezclado en la solución nutritiva en hidroponía, tratamiento a semilla, aplicación aérea en bajo volumen o como tratamiento en inmersión de semillas y frutos. Los mecanismos de acción involucrados en los efectos profilácticos de los fosfitos son diversos e incluyen la estimulación de los mecanismos de defensa bioquímica y estructural en las plantas, además de la acción directa que restringe el crecimiento, desarrollo y reproducción de los organismos fitopatógenos.
Palabras clave: fosfito de potasiofosfito de potasio,bioestimulantebioestimulante,control de fitopatógenoscontrol de fitopatógenos.
ABSTRACT: Phosphites are compounds derived from phosphorous acid used as an alternative for the control of phytoparasitic organisms and their effectiveness has been tested against protozoa, oomycetes, fungi, bacteria and nematodes; however, compared to conventional synthesized fungicides, phosphites are generally less effective at reducing damage by phytopathogens. The phosphite ion is easily transported in the plants via xylem and phloem, so it has been used in foliar application, drench of plant root and neck, injection trunk, through drip irrigation mixed in the nutrient solution in hydroponics, seed treatment, aerial application in low volume, or as treatment in immersion of seeds and fruits. The mechanisms of action involved in the prophylactic effects of phosphites are diverse and include the stimulation of biochemical and structural defense mechanisms in plants and direct action that restricts the growth, development and reproduction of phytopathogenic organisms.
Key words: potassium phosphite, biostimulant, control of phytopathogens.
Artículos de revisión
Los fosfitos como alternativa para el manejo de problemas fitopatológicos
Phosphites as alternative for the management of phytopathological problems
Sociedad Mexicana de Fitopatología A.C.
Recepción: 31 Octubre 2017
Aprobación: 22 Diciembre 2017
El uso irracional en la agricultura de pesticidas sintetizados, incrementa los problemas de contaminación ambiental, salud pública, disminución de la biodiversidad en los agroecosistemas y desarrollo de organismos fitopatógenos con resistencia, además, la comercialización agrícola actual demanda productos inocuos para los consumidores, provenientes de procesos con bajo impacto ambiental. Así, adquiere relevancia el control de enfermedades basado en el empleo de sales inorgánicas, que además de ser eficaces para el manejo de enfermedades en los cultivos muestren mínimas consecuencias adversas. Al respecto, Deliopoulos et al. (2010)reportan que se han utilizado 34 diferentes sales con esa finalidad, además indican que las sales de fosfito destacan por su frecuencia de utilización y eficacia en el control.
Los fosfitos son oxianiones derivados del ácido fosforoso (H3PO3-), que regularmente se combinan con cationes no metales como potasio, sodio, calcio o amonio. Los términos “fosfito” y “fosfanato” son comúnmente utilizados en la literatura para referirse a las sales derivadas del ácido fosforoso, al igual que “hidrogenofosfanatos”, “ortofosfitos”, “compuestos del ácido fosfónico” o “compuestos del ácido fosforoso” (Deliopoulos et al., 2010).
La diferencia química entre fosfato (H2PO4-) y fosfito (H2PO3-) es un átomo de oxígeno el cual es sustituido por otro de hidrógeno (Figura 1). La sustitución del oxígeno da lugar a profundas diferencias en la manera en que los fosfatos y fosfitos se comportan en los organismos vivos (McDonald et al., 2001; Achary et al., 2017). Debido a su similitud estructural, los fosfitos son considerados como análogos de los fosfatos, sin embargo, el uso de los fosfitos como fungicidas y bioestimulantes para el control de patógenos de plantas es ampliamente aceptado, pero su utilización como fuente de fósforo en la nutrición de plantas es actualmente debatida (Borza et al., 2014; Gómez-Merino y Trejo-Téllez, 2015; Alexandersson et al., 2016; Manna et al., 2016). Además, esa diferencia da a los fosfitos una mayor movilidad en el suelo y en los tejidos de las plantas, así como una mayor capacidad para penetrar a través de hojas, tallos y raíces (Tkaczyk et al., 2016).

Figura 1
Estructura del grupo fosfato (A) y fosfito (B).
El uso de los fosfitos en la agricultura, se ha investigado principalmente por su acción en el control de organismos fitoparásitos o como fuente de nutrición en plantas cultivadas (Gómez-Merino y Trejo-Téllez, 2015; Alexandersson et al., 2016). Esto último puede ocurrir únicamente si los fosfitos se aplican al suelo y entran en contacto con bacterias que tienen la capacidad de oxidarlos a fosfatos (McDonald et al., 2001; Manna et al., 2016). No obstante, este proceso es muy lento, y puede tomar hasta cuatro meses para completarse, lo que resulta impráctico para la agricultura (McDonald et al., 2001; Lovatt y Mikkelsen, 2006).
Fue a principios de 1930 cuando se concluyó que los fosfitos no eran fuente eficiente de fosforo para la nutrición de las plantas y 40 años después, regresó al mercado de los agroquímicos como alternativa para el manejo de enfermedades, cuando la compañía Francesa Rhône-Poulenc ofreció el ingrediente activo fosetil-aluminio para el control de mildius y enfermedades causadas por el género Phytophthora (Tkaczyk et al., 2016; Achary et al., 2017). Los fosfitos, como alternativa para el control de organismos fitoparásitos, han sido estudiados ampliamente y su eficacia se ha probado contra protozoarios, oomycetes, hongos, bacterias y nematodos fitoparásitos (Cuadro 1); adicionalmente, se ha comprobado su eficacia como bioestimulador (Gómez-Merino y Trejo-Téllez, 2015), para disminuir los daños por malezas (Manna et al., 2016; Achary et al., 2017) y radiación UV-B (Oyarburo et al., 2015).
Organismos fitoparásitos controlados con fosfitos.

Organismos fitoparásitos controlados con fosfitos.

El ion fosfito es fácilmente transportado en las plantas vía xilema y floema (McDonald et al., 2001; Tkaczyk et al., 2016), por lo que se ha utilizado en aplicación foliar (Rebollar-Alviter et al., 2010; Silva et al., 2011; Pagani et al., 2014; Yáñez et al., 2014; Liljeroth et al., 2016; Borza et al., 2017), baño a la raíz y cuello de la planta (Oka et al., 2007; Akinsanmi y Dreth, 2013), inyección al tronco (Bock et al., 2012; Akinsanmi y Drenth, 2013: Aćimović et al., 2015; Aćimović et al., 2016), a través de riego por goteo mezclado en la solución nutritiva en hidroponía (Förster et al., 1998), tratamiento a semilla (Abbasi y Lazarovits 2006; Lobato et al., 2008), aplicación aérea en bajo volumen (Hardy et al., 2001) o como tratamiento en inmersión de semillas y frutos (Anderson et al., 2012; Cerioni et al., 2013, Borin et al., 2017).
Los niveles de eficacia de los fosfitos en el control de organismos fitoparásitos varían dependiendo de: ión unido al fosfito, método de aplicación, organismo patógeno y planta hospedante (Cuadro 2; Figura 2); por ejemplo, la inmersión de frutos de mandarina en soluciones elaboradas con fosfito de calcio y potasio, sirvió para disminuir 50% de frutos dañados por moho verde de los cítricos, originado por Penicillium digitatum (Cerioni et al., 2013); también, plantas de soya tratadas con fosfito de potasio mostraron hasta 50% menos daño por Peronospora manshurica en comparación con las plantas sin tratar (Silva et al., 2011). Abbasi y Lazarovits (2006) reportan 80% menos plantas de pepino infectadas por Pythium spp. cuando las semillas fueron tratadas por inmersión en soluciones con fosfito de cobre. Ogoshi et al. (2013) obtuvieron disminución de 62.5% en la severidad de Colletotrichum gloeosporioides en plantas de café tratadas con fosfito de potasio. También, 93% de las plantas de papaya tratadas con fosfito de potasio sobrevivieron al ataque de Phytophthora palmivora, en contraste con el 24% de sobrevivencia de las plantas sin tratar (Vawdrey y Westerhuis, 2007).
Sensibilidad a fosfitos de patógenos en papa (Tomado de Lobato et al., 2010).

xConcentración del compuesto para inhibir el 50% de su crecimiento

Figura 2
Incidencia y severidad de Pseudoperonospora cubensis (A y A´) y Sphaerotheca fuliginea (B y B´) en plantas de pepino cultivadas en invernadero.
En comparación con los fungicidas convencionales sintetizados, los fosfitos generalmente son menos eficaces para disminuir el daño por los patógenos que atacan plantas, al respecto Méndez et al. (2010) consiguieron que plantas de melón tratadas con clorotalonil y mancozeb, mostraran menor daño por Pseudoperonospora cubensis que aquéllas que recibieron tratamiento con fosfito de potasio (Figura 3). También, Aćimović et al. (2016) lograron incidencia de Erwinia amylovora significativamente inferior con sulfato de estreptomicina, en comparación con la incidencia obtenida con fosfito de potasio, cuando esos compuestos se inyectaron al tallo de árboles de manzana (Figura 4). Meyer y Hausbeck (2013) reportaron disminución significativa en la incidencia de plantas de calabaza muertas por Phytophthora capsici, cuando fueron tratadas con los fungicidas fluopicolide, mandipropamid o dimethomorph, en comparación con la incidencia registrada en las plantas tratadas con fosfito de potasio. En general, los reportes comparativos de la eficacia en el control entre los fosfitos y los fungicidas convencionales, indican que los primeros son menos eficaces y que no los podrían sustituir por completo, pero su integración como parte de un programa de manejo integrado puede permitir disminuir el uso de fungicidas y reducir la posibilidad de generar resistencia por los organismos (Liljeroth et al., 2016). Al respecto, Méndez et al. (2010) determinaron eficacia similar en el combate de Pseudoperonospora cubensis en plantas de calabaza con clorotalonil/mancozeb y fosfito de potasio aplicados de manera alternada, comparada con la eficacia registrada cuando se utilizó únicamente los fungicidas (Figura 3). También, Liljeroth et al. (2016) reportaron que la protección contra Phytophthora infestans en papa, fue semejante cuando los fungicidas flluazinam, cyazofamida, mandipropamida, metalaxyl + flluazinam o flluopicolide + propamocarb, se usaron al 100% de la dosis recomendada o al 50% de la dosis en mezcla con fosfito de potasio.

Figura 3
Promedio del área bajo la curva del progreso de la enfermedad (ABCPE) obtenido con el tratamiento para el combate de Pseudoperonospora cubensis en plantas de pepino (Elaboración de los autores con datos de Méndez et al., 2010).

Figura 4
Control de Erwinia amylovora después de dos aplicaciones de inductor de resistencia o antibiótico, al tronco de árboles de manzana (Elaboración de los autores con datos de Aćimović et al., 2016).
Los mecanismos de acción involucrados en los efectos profilácticos de los fosfitos incluyen acción directa e indirecta. Se ha determinado que el ion fosfito al entrar en contacto con los organismos fitopatógenos, afecta su crecimiento y reproducción al influir en la expresión de genes que codifican la síntesis de compuestos indispensables en la estructura y fisiología celular (acción directa). Además, al entrar a las células del tejido vegetal (acción indirecta) activa los mecanismos bioquímicos (producción de: polisacáridos, proteínas relacionadas con la patogénesis, fitoalexinas, etc.) y estructurales de defensa (como la deposición de calosa) que restringen la penetración y supervivencia de los patógenos en la planta (Figura 5).

Figura 5
Modo de acción de los fosfitos, representación esquemática (Elaboración de los autores con datos de: Daniel y Guest, 2006; Jackson et al., 2000; King et al., 2010; Eshraghi et al., 2011; Olivieri et al., 2012; Cerioni et al., 2013; Dalio et al., 2014).
Los fosfitos adicionados al medio de cultivo para organismos fitopatógenos, originaron que disminuyera el crecimiento del micelio, el número de estructuras generadoras de esporas, la cantidad de esporas producidas y su germinación (Figura 6). Así, mediante esa práctica se reportó disminución en el crecimiento de Alternaria alternata (Reuveni et al., 2003), Colletotrichum gloeosporioides (Araujo et al., 2010), Fusarium culmorum y F. graminearum (Hofgaard et al., 2010), Mycosphaerella fijiensis (Mogollón y Castaño, 2012), Penicillium digitatum (Cerioni et al., 2013), Phytophthora cinnamomi (Wilkinson et al., 2001; Won et al., 2009; King et al., 2010), P. cinnamomi, P. palmivora y P. nicotianae (Smillie et al., 1989), P. infestans (Bórza et al., 2014), P. plurivora (Dalio et al., 2014) y Pythium aphanidermatum, P. ultimum, P. irregulare, P. myriotylum, P. torulosum, P. volutum y P. graminicola (Cook et al., 2009). El grado de disminución en el crecimiento de los microorganismos como consecuencia del ion fosfito, está determinado por el organismo ensayado, la cantidad de fosfito agregado al medio de cultivo, el tipo de ion unido al fosfito y el pH que se origine en el medio de cultivo (Lobato et al., 2010).

Figura 6
Crecimiento de Pythium aphanidermatum en medio de cultivo Papa-Dextrosa-Agar (izquierda) y agua destilada (derecha). A y A´ sin fosfito de potasio; B y B´ con fosfito de potasio.
La susceptibilidad de los microorganismos al ion fosfito fue comprobada por Wong et al. (2009), quienes determinaron el efecto negativo de fosfito y el positivo de fosfato sobre el crecimiento de Phythopthora cinnamomi, cuando creció en medio de cultivo enriquecido con sales que contenían cada ion de manera individual.
En relación a la susceptibilidad interespecífica, Hofgaard et al. (2010) obtuvieron disminuciones de 60, 80 y 90% en el crecimiento del micelio de Fusarium culmorum, F. graminearum y Microdochium majus, respectivamente, con 10 μl ml-1 de fosfito de potasio. Lobato et al. (2010) determinaron que para inhibir el crecimiento in vitro, la dosis menor se empleó para Phytophthora infestans, seguida de la usada para inhibir a Streptomyces scabies, Rhizoctonia solani y Fusarium solani.
La susceptibilidad intraespecífica fue estudiada por Wilkinson et al. (2001), quienes determinaron que de 21 aislamientos de Phytophthora cinnamomi colectados en el oeste de Australia, 9% resultaron susceptibles a fosfito de potasio, 82% mostraron susceptibilidad intermedia y 9% fueron tolerantes. Smillie et al. (1989) determinaron la susceptibilidad de Phytophthora cinnamomi, P. palmivora y P. nicotiana a fosfito de potasio, explicando además que a medida que la concentración de fosfito se incrementó en el medio de cultivo, disminuyó el peso de la biomasa producida por las tres especies de Phytophthora. También Cook et al. (2009) evaluaron la concentración necesaria de fosfito y el fungicida mefenoxan, para inhibir el 50% del crecimiento del micelio de ocho aislamientos de Pythium aphanidermatum, y reportaron que todos los aislamientos fueron susceptibles a los dos compuestos, pero que las concentraciones de fosfito utilizadas fueron mayores que las del fungicida.
Por otro lado, el ion fosfito disminuyó el pH en el medio de cultivo a niveles de acidez que se relacionaron con menor crecimiento de Phytophthora infestans, Rhizoctonia solani, Fusarium solani y Streptomyces scabies (Lobato et al., 2010). Araujo et al. (2010) reportaron mayor diminución del diámetro de las colonias y el índice de velocidad de crecimiento de Colletotrichum gloeosporioides, con formulaciones de fosfito de potasio que originaron mayor disminución del pH en el medio de cultivo. Además, fosfito de potasio afectó la germinación de esporas de Alternaria alternata (Reuveni et al., 2003), Colletotrichum gloeosporioides (Ogoshi et al., 2013), Penicillium digitatum (Cerioni et al., 2013), P. expansum (Amiri y Bompeix, 2011) y Peronospora parasitica (Becót et al., 2000); así como la producción de esporas de Fusarium oxysporum f sp. cubense (Davis y Grant, 1996), Mycosphaerella fijiensis (Mogollón y Castaño, 2012), Peronospora sparsa (Hukkanen et al., 2008), Phytophthora plurivora (Dalio et al., 2014) y P. cinnamomi (Wong et al., 2009).
El efecto de los fosfitos agregados al medio de cultivo fue explicado por King et al. (2010), quienes reportaron modificación inducida por fosfito de potasio en la expresión de genes que codifican la síntesis de proteínas que constituyen la pared y el citoesqueleto de las células de Phytophthora cinnamomi, lo que originó distorsión de hifas y lisis de pared celular.
La acción indirecta del ión fosfito incluye la estimulación de los mecanismos de defensa estructural y bioquímica en las plantas; así, Pilbeam et al. (2011) describieron deposición de lignina y suberina alrededor del tejido dañado por Phytophthora cinnamomi en plantas de eucalipto tratadas con fosfito de potasio, efecto que limitó el desarrollo del patógeno. También Olivieri et al. (2012) refirieron aumento en el contenido de pectina en el tejido de la peridermis y la corteza, en tubérculos procedentes de plantas de papa tratadas con fosfito de potasio, condición que mejora la resistencia a diversos patógenos. Jackson et al. (2000) reportaron que el desarrollo de lesiones por P. cinnamomi fue altamente restringido, cuando la concentración de fosfito en el tejido de Eucalyptus marginata fue alta y la disminución en el desarrollo de lesiones se asoció con un aumento significativo de las enzimas de defensa (4-coumarato coenzima A ligasa y deshidrogenasa de alcohol cinnamyl) y de fenoles solubles. Daniel y Guest (2006) demostraron que en plántulas de Arabidopsis thaliana, tratadas con fosfito de potasio e inoculadas con zoosporas de Phytophthora palmivora, las células infectadas aumentaron la actividad citoplasmática, el desarrollo de agregados citoplasmáticos, la liberación de peróxido de hidrógeno, muerte celular localizada y mejoraron la acumulación de compuestos fenólicos. Eshraghi et al. (2011) también reportaron que en plántulas de Arabidopsis thaliana, tratadas con fosfito de potasio e inoculadas con Phytophthora cinnamomi, la producción de calosa y de peróxido de hidrógeno se incrementó en las células infectadas.
Los fosfitos son compuestos eficaces para el control de protozoarios, oomycetes, hongos, bacterias y nematodos fitoparásitos, sin embargo, en comparación con los fungicidas convencionales sintetizados suelen ser menos eficaces. Los niveles de eficacia de los fosfitos para resolver problemas fitopatológicos están en relación con: organismo problema, planta hospedante e ion unido al fosfito. Por su eficiente translocación en tejido vegetal, se pueden suministrar al follaje, tallos, raíces o frutos. Los mecanismos de acción involucrados en los efectos profilácticos de los fosfitos son diversos e incluyen la estimulación de los mecanismos de defensa bioquímica y estructural en las plantas, además de la acción directa que restringe el crecimiento, desarrollo y reproducción de los organismos fitoparásitos. La integración de los fosfitos como parte de un programa de manejo de problemas fitopatológicos permite disminuir el número de aplicaciones de fungicidas y reducir la posibilidad de generar resistencia por los organismos fitoparásitos.
* Autor para correspondencia: tafoya@uas.edu.mx.

Figura 1
Estructura del grupo fosfato (A) y fosfito (B).
Organismos fitoparásitos controlados con fosfitos.

Organismos fitoparásitos controlados con fosfitos.

Sensibilidad a fosfitos de patógenos en papa (Tomado de Lobato et al., 2010).

xConcentración del compuesto para inhibir el 50% de su crecimiento

Figura 2
Incidencia y severidad de Pseudoperonospora cubensis (A y A´) y Sphaerotheca fuliginea (B y B´) en plantas de pepino cultivadas en invernadero.

Figura 3
Promedio del área bajo la curva del progreso de la enfermedad (ABCPE) obtenido con el tratamiento para el combate de Pseudoperonospora cubensis en plantas de pepino (Elaboración de los autores con datos de Méndez et al., 2010).

Figura 4
Control de Erwinia amylovora después de dos aplicaciones de inductor de resistencia o antibiótico, al tronco de árboles de manzana (Elaboración de los autores con datos de Aćimović et al., 2016).

Figura 5
Modo de acción de los fosfitos, representación esquemática (Elaboración de los autores con datos de: Daniel y Guest, 2006; Jackson et al., 2000; King et al., 2010; Eshraghi et al., 2011; Olivieri et al., 2012; Cerioni et al., 2013; Dalio et al., 2014).
Figura 6
Crecimiento de Pythium aphanidermatum en medio de cultivo Papa-Dextrosa-Agar (izquierda) y agua destilada (derecha). A y A´ sin fosfito de potasio; B y B´ con fosfito de potasio.
